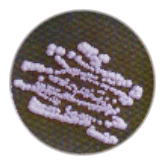

|
| Zurück |
Hefepilze im Darm -
Gastroenterologische und immunologische Aspekte
Mykosen werden beim Menschen vor allem vom fakultativen pathogenen Erreger Candida albicans verursacht. Die pathogenetische Bedeutung dieses Keimes für Patienten mit Immunschwäche (Intensivpatienten, Patienten unter Tumortherapie usw.) ist allg. unstrittig. Überdie Relevanz von Candida alb. wird in der ambulanten Medizin vielfach kontrovers und emotional diskutiert.Bei nicht wenigen Patienten spielt aber die Candida-Infektion eine erhebliche Rolle. Diese Patienten haben vielfach eine Odysse hinter sich und verlieren oft das Vertrauen zu ihren Hausärzten bzw. zur medizinischen Betreuung. Wir möchten dieses Thema aufgreifen und in kurzer Form unsere Erfahrungen den ärztlichen Kolleginnen und Kollegen übermitteln.
Neben dem häufigsten Vertreter der humanpathogenen Candida-spezies dem Candida albicans (ca. 90% aller Mykosen in unserem Raum) sind weiterhin Candida glabrata, Candida krusei, Candida guilliermondii, Candida tropicals, Candida parapsolosis, Candida pseudotropicals mehr oder weniger verbreitet.
Candida albicans
auf Kimmig-AgarWir finden diese Hefepilze in den verschiedensten Bereichen des Organismus. Candida albicans hält sich hauptsächlich im Oro-Gastrointestinaltrakt auf. Bei etwa 30% der Bevölkerung werden Candida-Hefen im Oro-Gastrointestinaltrakt nachgewiesen.
Die Befallsstärke ist in der Regel gering und der alleinige Nachweis von Candidaspezies ist nicht unbedingt als pathologischer Befund zu bewerten. Die klinische Symtomatik ist ausschlaggebend für eine spezifische immunologische Diagnostik bzw. zur Erfassung einer klinisch-pathologischen Candida-Infektion. Patienten mit Immundefekten resp. Immunschwäche bes. im Bereich der zellulären Abwehr, Immunschwäche nach Streß (Burnout-S. Fatigue-S.), Umweltbelastungen, immunologischen Dysregulationen, immun-pathogenen Erkrankungen wie Überempfindlichkeitsreaktionen der verschieden Typen, Autoimmunerkrankungen und nach Behandlungen mit Antibiotika, Zytostatika begünstigen die Ausbreitung und Vermehrung des Pilzes.
Die klinischen Symptome sind außerordentlich vielschichtig, es bestehen vielfach Müdigkeit, Abgeschlagenheit, zeitweise Diarrhöen, Nahrungsmittel-Überempfindlichkeiten, Gelenkbeschwerden, Oberbauchbeschwerden, Beschwerden ähnlich dem rheumatischen Formkreisen u.a.
Unter den o.g. Bedingungen ist Candida alb. nach Adhäsion mit den Zellen der Darmschleimhaut in der Lage eine Reaktionskaskade ablaufen zu lassen und das immunologische Gleichgewicht bes. der TH1 /TH2-Lymphozyten zu seinen Gunsten zu verschieben. Candida alb. kann die immunologischen Reaktionen so modulieren, dass letztendlich die Abwehrlage des Patienten reduziert wird.
Es ist grundsätzlich davon auszugehen, dass die Pathogenese der intestinalen Sprosspilzbesiedlung entscheidend von einer funktionsfähigen Immunabwehr des besiedelten Organismus abhängig ist.Zur Beurteilung der klinischen Relevanz reicht die quantitative Bestimmung der Candidakolonien in den Stuhlproben nicht aus. Erst immunologische Parameter zur Erfassung der Funktionsfähigkeit des Immunsystems objektivieren beim Patienten den tatsächlichen Krankheitszustand. Eine aussagekräftige Untersuchung des Immunstatus im Rahmen eines intestinalen Candidabefalles muß humorale wie zellulären immunologische Tests einschließen, da alle Immunmechanismen in die Wechselbeziehungen zwischen Sproßpilzen und dem Wirtsorganismus integriert sind.
Auf humoraler Ebene sezerniert das darmassoziierte Immunsystem, dass in der Lamina propria zu finden ist, neben IgG und IgM besonders Antikörper der Klasse A. Eine optimale funktionsfähige Immunantwort regelt die T-B-Zellkooperation und es kommt nicht zum Krankheitsbild der Sproßpilzinfektion.
Die immunologische Wechselwirkung beginnt in der Mukosa mit der Antigenaufnahme der Stoffwechselprodukte der Pilze resp. deren Myzelien oder Pseudomyzelien durch spezialisierte M-Zellen und Makrophagen. Danach erfolgt eine Antigenpräsentation gegenüber den nativen T-Helfer-Zellen (CD4-Zellen) die über Zytokine die benachbarten B-Lymphozyten aktivieren. Über die immunologische Kaskade werden vielfach Immunzellen zur Aktivierung und zur Synthese von Antikörpern und Zytokinen angeregt; denn zwischen den verschiedenen Immunzellen findet ein enger Informationsaustausch statt. So bestehen Vernetzungen zwischen immunkompetenten Zellen des Darmes und den Alveolarmakrophagen, diese wiederum kommunizieren mit Milzmakrophagen usw.
So ist es nicht verwunderlich, dass eine Candida-Infektion Auswirkungen auf die Immunreaktionen im gesamten Organismus hat. Bei diesen Reaktionen spielt die Anzahl der Candida-Keimzahlen im Stuhl keine Rolle. Ausschlaggebend ist das reagierende Immunsystem des jeweiligen Organismus.Bekannt sind enge Verbindungen zwischen Candida-Infektionen und Allergien sowie Hautreaktionen. Über die o.g. Candida induzierten Immunreaktionen im Darm auf die TI-12-Zellen, gewinnen diese die Oberhand über den Gegenspieler, die THI-Zellen. Diese Reaktionen haben zur Folge, dass das von den TH2-Zellen produzierte Interleukin- 4 (IL-4) in relativ hoher Dosierung freigesetzt wird und die Synthese des Interferon-7 (IFN-7 ) welches vor allem von THI-Zellen synthetisiert wird, drosselt.
Weiterhin stimuliert IL-4 die Differenzierung von B-Lymphozyten in IgE-produzierenden Plasmazellen. Die Reduktion von IFN-7 hat zur Folge, dass Makrophagen und andere Phagozyten in ihrer Aktivität gehemmt werden. Auf diese Weise können sich u.a. Krankheitserreger ausbreiten und das Immunsystem unterlaufen. Durch die vermehrte Freisetzung von IgE, die gegen bestimmte Antigene, so auch gegen Candida-Antigene gerichtet sind, werden Mastzellen sensibilisiert.
Es können nach Degranulation der Mastzellen verschiedene Mediatoren u.a. Histamin freigesetzt werden. Es kommt zu einer allergischen Reaktion vom E-Typ oder G-Typ.
In der Sproßpilzdiagnostik spielen die Bestimmungen der Antikörper der Klassen G, A und M eine wesentliche Rolle. Werden keine Antikörper gebildet, so kann davon ausgegangen werden, dass keine Immunantwort besteht, auch bei bestehender Besiedlung des Darmes. Erst nach Verlassen des Darmlumens, wenn der Pilz in die Darmwand eindringt, kommt es zu Kontakten mit dem Immunsystem und zur Immunantwort.
Der Nachweis der verschiedenen Antikörperklassen gibt Aufschluß über den Verlauf der Infektion. Deutlich erhöhte Antikörper der Klasse M bei gleichzeitig niedrigen IgG-Titern belegen eine akute Infektion. Antikörper der Klasse IgA (ohne IgM) weisen auf eine Langzeitinfektion hin. Die Titerhöhe der IgG sind ausschlaggebend für eine bestehende aktive Immunantwort oder auch bei geringen Titern für das „Unterlaufen" der humoralen Immunantwort. In diesen Fällen ist eine Differenzierung des T-Helfer-Subset, der TH1- und TH2-Zellen unbedingt angebracht.
Zur weiteren Diagnostik ist der Nachweis unspez. Antigene anderer Hefepilze mit Hilfe der Immunhämagglutination außerordentlich sinnvoll. Dieser Test erfaßt aufgrund der Antigengemeinsamkeiten gleichzeitig Anitkörper gegen C. albicans, C. tropicalis u.a. Die angebotenen immunologischen Tests der verschiedenen Firmen unterscheiden sich in der Spezifität und Sensitivität z.T. ganz erheblich.
Die ermittelten Werte müssen mit der Klinik in Übereinstimmung gebracht werden und die Laboratorien sind für ihre Testergebnisse mit verantwortlich.Wie oben dargestellt wurde, erhöht die Dysregulation des Immunsystems eine klinisch/pathologisch relevante Manifestation einer Candida-Infektion und aus diesem Grunde sollte neben einer möglichen antimykotischen Therapie (die lediglich die Keimlast reduziert) unbedingt eine Stabilisierung der Immunitätslage durch eine Immuntherapie vorgenommen werden. Voraussetzung jedweder Immuntherapie ist das Wissen über die Art der Immunreduktion. Durch eine gezielte kombinierte Therapie (Mykosebehandlung, Immuntherapie, Allergiebehandlung) kann eine langfristige Behandlung der Candida-Infektionen vorgenommen werden.
Aspergillus fumigatus
auf Kimmig-Agar
Konidien Aspergillus-niger
auf Kimmig-Agar
Pseudomyzel
von Candida albicans


